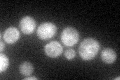
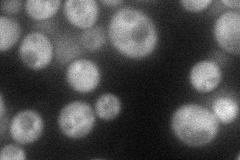
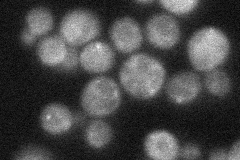
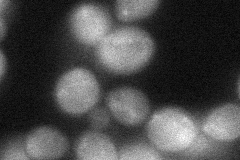
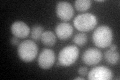

View description
A guanine nucleotide exchange factor involved in vesicle-mediated vacuolar protein transport; specifically stimulates the intrinsic guanine nucleotide exchange activity of Vps21p/Rab5: similar to mammalian ras inhibitors; binds ubiquitin
Localization:
Intensity:
Fold change:
Significance:
-
C’ GFP library in SD
cytosol32.94 -
N' NOP1pr-GFP in SD
cytosol,punctate51.9739 -
N' TEF2pr-mCherry in SD

cytosol,punctate76.1161 -
N' NATIVEpr-GFP in SD
cytosol,punctate36.3248 -
N' TEF2pr-VC and Cyto-VN in SD
cytosol43.597 -
C’ GFP library in SD+DTT
cytosol34.631.05No -
C’ GFP library in SD+H2O2

cytosol32.520.98No -
C’ GFP library in Starvation Media

cytosol21.920.66No -
C’ GFP library on the background of Pup2-DaMP

cytosol -
C’ GFP library on the background of CCT mutant

cytosol33.71981.02323No
